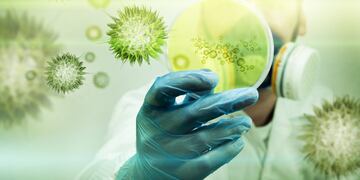

Este sábado desde el COE Regional informaron que 31 personas arrojaron resultados positivos de COVID-19, sumando un nuevo fallecido. Se trata de una mujer de 75 años de edad que se mantenía en terapia intensiva del Hospital Iturraspe. De esta manera la cantidad de casos activos en San Francisco es de 262 personas.
Diecinueve personas continúan hospitalizadas, diez de ellas con asistencia respiratoria en el Hospital Iturraspe, mientras que el total de aislados en San Francisco subió a 1834 ciudadanos. Desde el inicio de la pandemia se registraron 6363 positivos de los cuales 6036 ya cuentan con el alta médica.

La Francia
Registro 1 nuevo caso en la jornada del sábado. No hubo nuevos fallecidos en La Francia y la cantidad de casos activos ascendió a 12 personas.